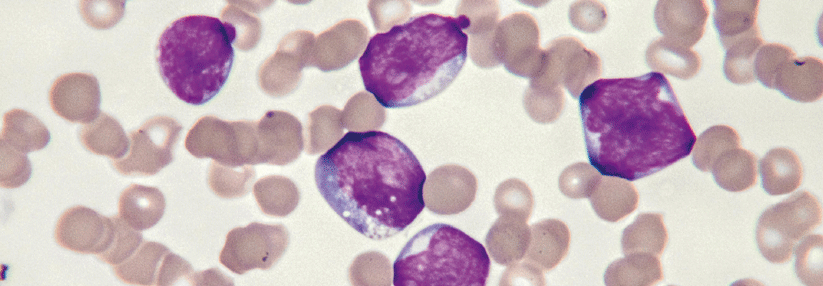

Ph+ ALL Ohne Chemo und Transplantation
 In der Erstlinien-Kohorte zeigte sich früh ein Ansprechen.
© iStock/ koto_feja
In der Erstlinien-Kohorte zeigte sich früh ein Ansprechen.
© iStock/ koto_feja
Standard für Erkrankte mit neu diagnostizierter Philadelphia-Chromosom-positiver akuter lymphatischer Leukämie (Ph+ ALL) ist die Kombination aus einer Chemotherapie und einem TKI. In einer neuen Phase-2-Studie prüften Forschende eine Alternative: Mit Ponatinib plus Blinatumomab in der Erstlinie erreichten 85 % der Patient:innen ein komplettes molekulares Ansprechen (CMR), berichtete Prof. Dr. Nicholas J. Short vom MD Anderson Cancer Center in Houston. Bei Erkrankten mit rezidivierter oder refraktärer (r/r) Ph+ ALL war die Rate mit 79 % ebenfalls hoch, während Betroffene mit chronisch myeloischer Leukämie in lymphoid akzellerierter Phase oder Blastenkrise (CML-LBC) nur zu 33 % komplett…
Bitte geben Sie Ihren Benutzernamen und Ihr Passwort ein, um sich an der Website anzumelden.



